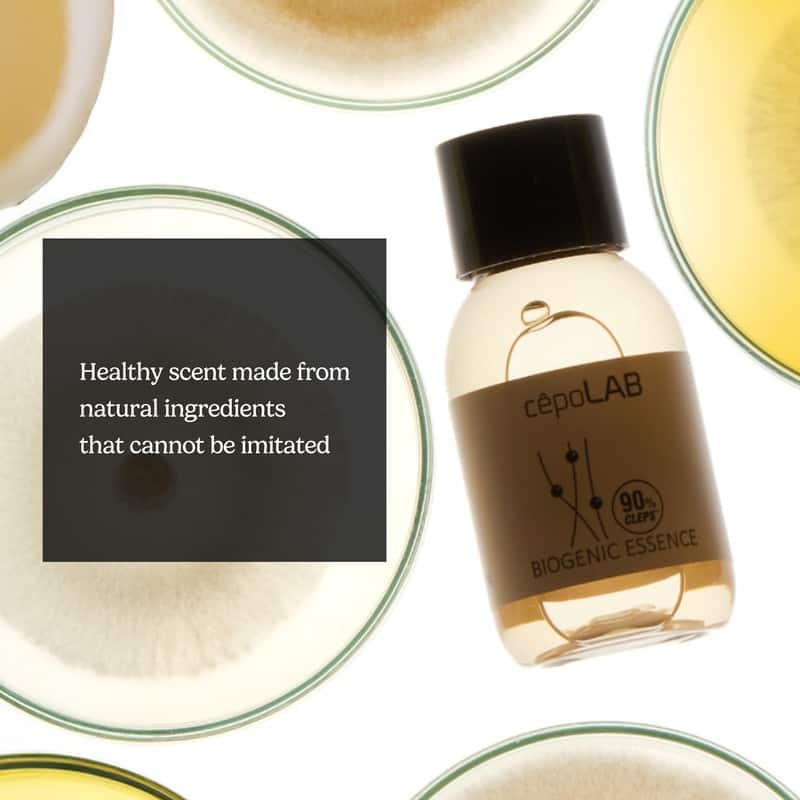
cepoLAB Biogenic Essence 90percent (2 types) - Bright Yellow

cepoLAB Biogenic Essence 90percent (2 types) - Bright Yellow

cepoLAB Biogenic Essence 90percent (2 types) - Bright Yellow
cepoLAB Biogenic Essence is a revolutionary pre-care essence designed to closely resemble the original culture solution, featuring 92.8% CLEPS™, a powerful physiological active substance derived from Ceriporia lacerata vesicles.
With Cellular Life Energy Preservation System (CLEPS™) technology, this essence deeply penetrates the skin, delivering essential nourishment while reinforcing its natural strength and vitality.
Clinically tested, it has been proven to improve 14 key skin health indicators within 1, 2, and 4 weeks, offering progressive benefits over time.
With a pure and minimal formula, it is free from colorants, fragrances, and harmful additives, making it safe even for sensitive skin.
Since 2023, cepoLAB Biogenic Essence has sold over 3 million bottles, achieving an annual growth rate of 262.7%, solidifying its position as a game-changer in skincare. Experience the ultimate skin transformation with cepoLAB Biogenic Essence – the purest essence with true originality.
* How to use
1. After cleansing, apply the biogenic essence immediately.
2. Layer it three times to ensure it is fully absorbed into the skin.
3. Finish with your regular skincare products.
• Improving 14 key skin health indicators
• Moisturizing
• For people who have dry skin
• Eco-package for Nature
* Ingredients:
Ceriporia Lacerata Vesicles, Butylene Glycol, 1,2-Hexanediol, Hydroxyacetophenone, Sodium Hyaluronate
* Features:
Skin strengthening, Skin elasticity, Pore care, Skin translucency, Anti-aging, Moisturizing (hydration), Absorption, Trouble care
Disclaimers & Disclosures:
Non-Returnable Item - This item is non-returnable.
- Skin Type
- Any
- Type
- Blemish & Acne Treatment, Face Serum
- Dimensions
- 1.34 In. L X 1.34 In. W X 2.83 In. H
- Model Number
- CPL-BE30ML-1
- Country of Origin
- South Korea
- Product Features
- Anti-Aging
- Warranty
- 1 year Manufacturer